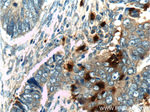
PRTN3 Antibody in Immunohistochemistry (Paraffin) (IHC (P))

Search
Proteintech
PRTN3 Polyclonal Antibody
{{$productOrderCtrl.translations['antibody.pdp.commerceCard.promotion.promotions']}}
{{$productOrderCtrl.translations['antibody.pdp.commerceCard.promotion.viewpromo']}}
{{$productOrderCtrl.translations['antibody.pdp.commerceCard.promotion.promocode']}}: {{promo.promoCode}} {{promo.promoTitle}} {{promo.promoDescription}}. {{$productOrderCtrl.translations['antibody.pdp.commerceCard.promotion.learnmore']}}
产品信息
25278-1-AP
种属反应
宿主/亚型
分类
类型
抗原
偶联物
形式
浓度
规格
纯化类型
保存液
内含物
保存条件
运输条件
产品详细信息
Immunogen sequence: RAAEIVGGH EAQPHSRPYM ASLQMRGNPG SHFCGGTLIH PSFVLTAAHC LRDIPQRLVN VVLGAHNVRT QEPTQQHFSV AQVFLNNYDA ENKLNDVLLI QLSSPANLSA SVATVQLPQQ DQPVPHGTQC LAMGWGRVGA HDPPAQVLQE LNVTVVTFFC RPHNICTFVP RRKAGICFGD SGGPLICDGI IQGIDSFVIW GCATRLFPDF FTRVALYVDW IRSTLRRVEA KGRP (24-256 aa encoded by BC096183)
靶标信息
Serine protease that degrades elastin, fibronectin, laminin, vitronectin, and collagen types I, III, and IV (in vitro) (PubMed:3198760, PubMed:2033050, PubMed:28240246). By cleaving and activating receptor F2RL1/PAR-2, enhances endothelial cell barrier function and thus vascular integrity during neutrophil transendothelial migration (PubMed:23202369). May play a role in neutrophil transendothelial migration, probably when associated with CD177 (PubMed:22266279). [UniProt]
仅用于科研。不用于诊断过程。未经明确授权不得转售。
生物信息学
蛋白别名: AGP7; azurophil granule protein 7; C-ANCA antigen; Leukocyte proteinase 3; Myeloblastin; Neutrophil proteinase 4; NP-4; P29; PR-3; serine proteinase, neutrophil; unnamed protein product; Wegener autoantigen; Wegener granulomatosis autoantigen
基因别名: ACPA; AGP7; C-ANCA; CANCA; MBN; MBT; NP-4; NP4; P29; PR-3; PR3; PRTN3
UniProt ID: (Human) P24158
Entrez Gene ID: (Human) 5657